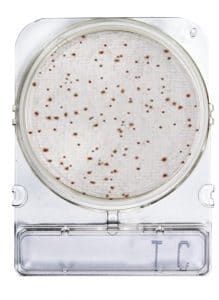

COMPACT DRY TC (RECUENTO TOTAL)
- gotowe do użycia, odwodnione, selektywne i chromogenne podłoża na płytkach
- alternatywa dla klasycznych płytek Petriego
- skracają czas analizy mikrobiologicznej
- minimalna przestrzeń inkubacji
- prostota użytkowania i niezawodne wyniki
- okres przechowywania 2 lata w temp. pokojowej
Wpisz kod pocztowy, aby skontaktować się z najbliższym doradcą w Twoim regionie.
Opis:
Compact Dry to prosta i bezpieczna metoda oznaczania i ilościowego określania mikroorganizmów w produktach spożywczych, kosmetykach oraz innych surowcach, w tym w produktach farmaceutycznych. Gotowe do użycia chromogenne płytki Compact Dry nadają się zarówno do kontroli w trakcie procesu, jak i do kontroli końcowego produktu.
Dzięki wskaźnikom redoks i substratom chromogennym kolonie bakteryjne wyrastają w specyficznych kolorach, co umożliwia ich łatwe rozróżnienie i identyfikację. W celu przeprowadzenia dalszych analiz można bez trudu wyizolować poszczególne kolonie. Kolonie bakterii tlenowych przybierają czerwoną barwę dzięki obecności soli tetrazolowej (wskaźnik redoks), co ułatwia ich odróżnienie od ewentualnych resztek żywności.
Specyfikacja:
- Matryca: Surowce, produkty gotowe, próbki środowiskowe z przemysłu spożywczego, kosmetycznego i farmaceutycznego oraz innych branż.
- Czas i temperatura inkubacji: AOAC: Inkubacja w temperaturze 35 ± 2°C przez 48 ± 3 godziny. NordVal i MicroVal: Inkubacja w temperaturze 30 ± 1°C przez 48 ± 3 godziny.
- Prezentacja: Opakowania zawierające 4 jednostki.
Sposób użycia:
- Zdjąć pokrywę.
- Umieścić 1 ml próbki na środku powierzchni płytki Compact Dry.
- Próbka automatycznie i równomiernie rozprowadza się na folii, przekształcając suchą folię w żel w ciągu kilku sekund.
- Nałożyć ponownie pokrywę na płytkę. Inkubować przez określony czas.
| Opakowanie | 20 szt. |
|---|